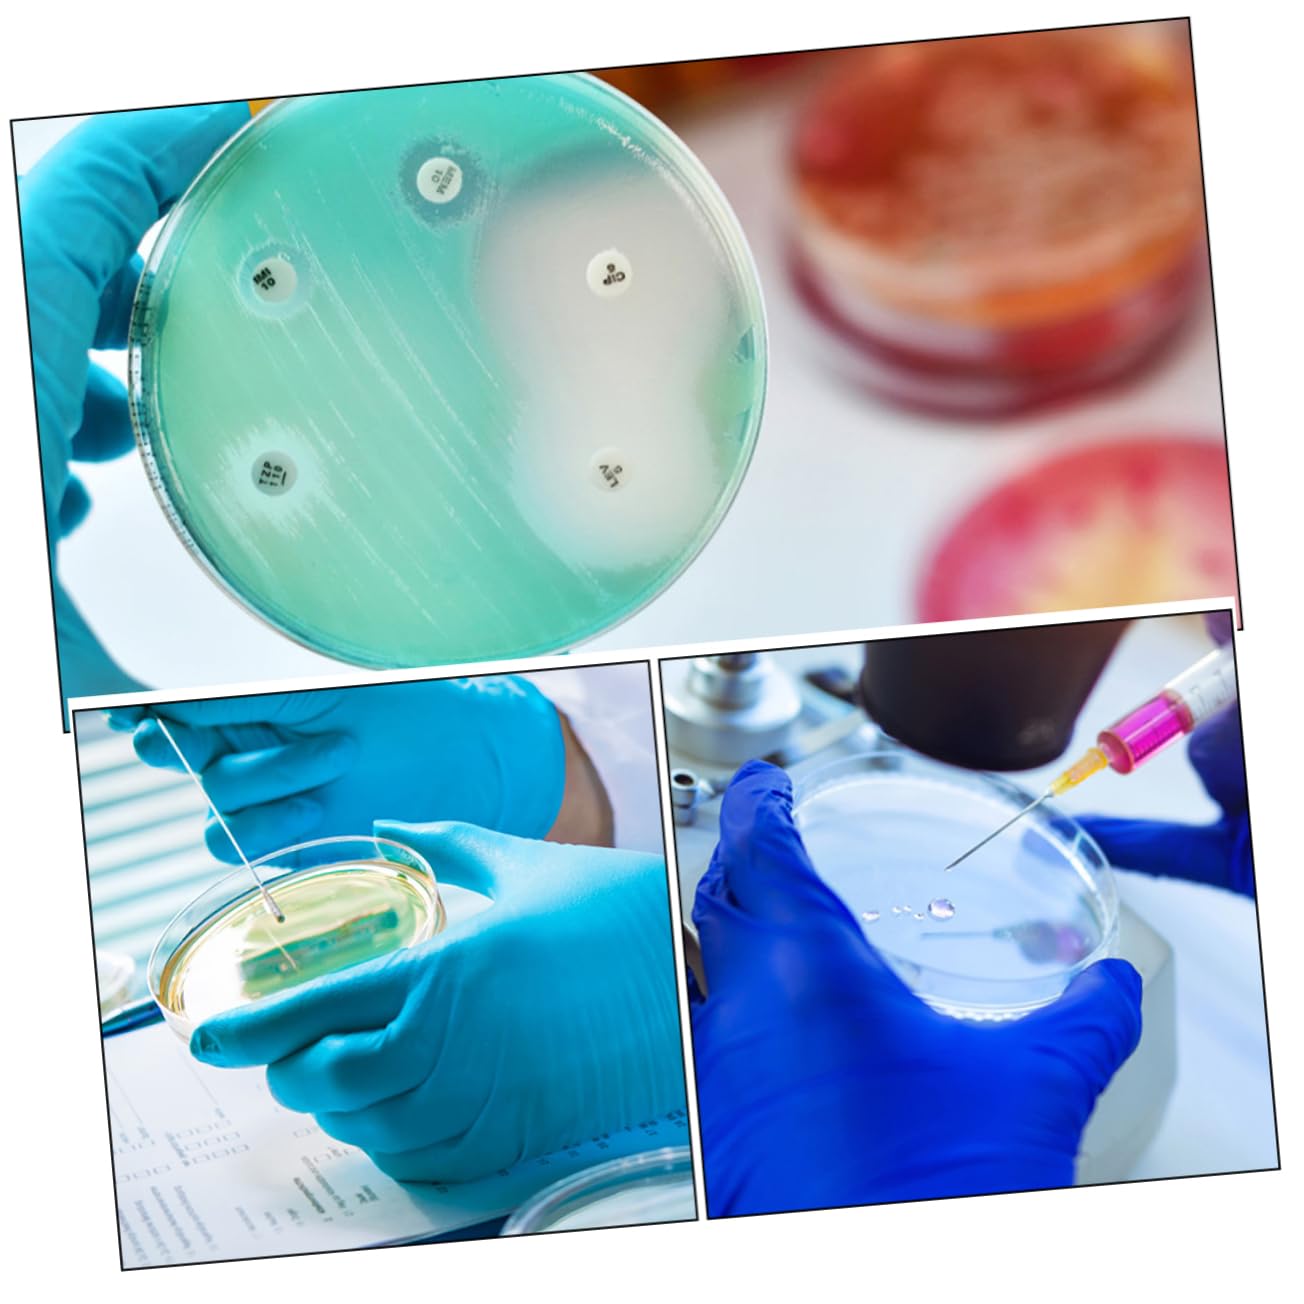
KICHOUSE 2sets Science Supplies Reaction Plate Tissue Culture Dish with Lid Lab Science Experiment Supplies 10pcs*2

Product Information
Specification
Brand : KICHOUSE
BulletPoint1 : Petri dish--laboratory analysis for medical, , scientific research and other activities, suitable for general training,agar petri dishes
BulletPoint2 : Petri dishes with lids--wonderful detail design and good craftsmanship will ensure its durability and practicality,science petri dishes
BulletPoint3 : Culture plate--suitable for classroom teaching, chemistry experiment, and also fit for laboratory use,plastic petri dish
BulletPoint4 : Clear culture plate--easy to observe with transparent and clear look design, and the bottom of the flat and smooth,plastic petri plates
BulletPoint5 : Petri dishes--the cell culture plate is easy and simple to use, excellent and reliable, bring much convenience to you,science experiment supplies
Color : As Shown
ExternallyAssignedProductIdentifier : 8889712669178
ItemDisplayDimensions_Length : 1.38 centimeters
ItemDisplayWeight : 0.15 pounds
ItemName : KICHOUSE 2sets Science Supplies Reaction Plate Tissue Culture Dish with Lid Lab Science Experiment Supplies 10pcs*2
ItemPackageDimensions_Height : 3.15 inches
ItemPackageDimensions_Length : 5.51 inches
ItemPackageDimensions_Width : 1.97 inches
ItemPackageQuantity : 1
ItemTypeKeyword : science-lab-petri-dishes
ItemVolume : 1 cubic_centimeters
Manufacturer : KICHOUSE
Material : plastic
ModelNumber : P2Y016025E4
NumberOfItems : 1
NumberOfLithiumMetalCells : 1
PartNumber : P2Y016025E4
ProductDescription : Package List
20 x Petri Dishes with Lids
Features
- Color: As Shown labs experiment device
-Material:Plastic tissue culture plate
- Size: 3.50X3.50X1.50cm/1.38X1.38X0.59in petri dish
- Wonderful detail design and good craftsmanship will ensure its durability and practicality petri dishes.
- The cell culture plate is easy and simple to use, excellent and reliable, bring much convenience to you chemistry petri dish.
- This petri dish plate are excellent and and useful function, suitable for research use culture
- Easy to observe with transparent and clear look design, and the bottom of the flat and smooth petri dish plates.
- Clear appearance and low expansion rate, moderate thickness, not easy to broke, practical and excellent transparent cell culture
Goods Information
culture petri dishes The professional petri dish, made of plastic material, is practical and transparent design.laboratory petri dish Every culture plate is reliable and practical design, which is useful tool for you in science experiment.culture plate for lab Suitable and wonderful for laboratory experiment, and scientific research, etc
ProductSiteLaunchDate : 2024-10-27T21:45:44.608Z
Size : medium
SupplierDeclaredDgHzRegulation : not_applicable
TheatricalReleaseDate : 2024-09-15T07:00:00.000Z
UnspscCode : 41000000